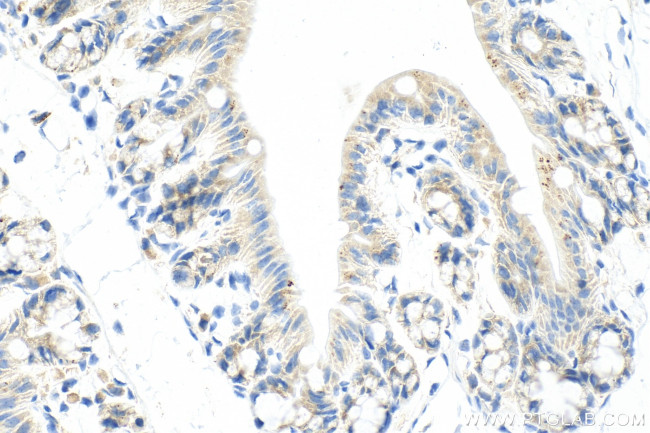
RNF160 Antibody in Immunohistochemistry (Paraffin) (IHC (P))

Search
Proteintech
RNF160 Recombinant Rabbit Monoclonal Antibody (230075H2)
{{$productOrderCtrl.translations['antibody.pdp.commerceCard.promotion.promotions']}}
{{$productOrderCtrl.translations['antibody.pdp.commerceCard.promotion.viewpromo']}}
{{$productOrderCtrl.translations['antibody.pdp.commerceCard.promotion.promocode']}}: {{promo.promoCode}} {{promo.promoTitle}} {{promo.promoDescription}}. {{$productOrderCtrl.translations['antibody.pdp.commerceCard.promotion.learnmore']}}
产品信息
82926-1-RR
种属反应
宿主/亚型
Expression System
分类
类型
克隆号
抗原
偶联物
形式
浓度
纯化类型
保存液
内含物
保存条件
运输条件
产品详细信息
Immunogen sequence: MGGKNKQRTK GNLRPSNSGR AAELLAKEQG TVPGFIGFGT SQSDLGYVPA IQGAEEIDSL VDSDFRMVLR KLSKKDVTTK LKAMQEFGTM CTERDTETVK GVLPYWPRIF CKISLDHDRR VREATQQAFE KLILKVKKQL APYLKSLMGY WLMAQCDTYT PAAFAAKDAF EAAFPPSKQP EAIAFCKDEI TSVLQDHLIK ETPDTLSDPQ TVPEEEREAK FYRVVTCSLL ALKRLLCLLP DNELDSLEEK FKSLLSQNKF WKYGKHSVPQ IRSAYFELVS ALCQRIPQLM KEEASKVSPS
靶标信息
ZNF294 may function as an E3 ubiquitin-protein ligase. E3 ubiquitin ligases accept ubiquitin from an E2 ubiquitin-conjugating enzyme in the form of a thioester and then directly transfer the ubiquitin to targeted substrates.
仅用于科研。不用于诊断过程。未经明确授权不得转售。
篇参考文献 (0)
生物信息学
蛋白别名: E3 ubiquitin-protein ligase listerin; RING finger protein 160; RING-type E3 ubiquitin transferase listerin; Zfp-294; Zinc finger protein 294
基因别名: 4930528H02Rik; AV266914; C21orf10; C21orf98; C87237; HSPC087; KIAA0714; Lister; Listerin; LTN1; RNF160; Zfp294; ZNF294
UniProt ID: (Human) O94822, (Mouse) Q6A009
Entrez Gene ID: (Human) 26046, (Mouse) 78913, (Rat) 288308